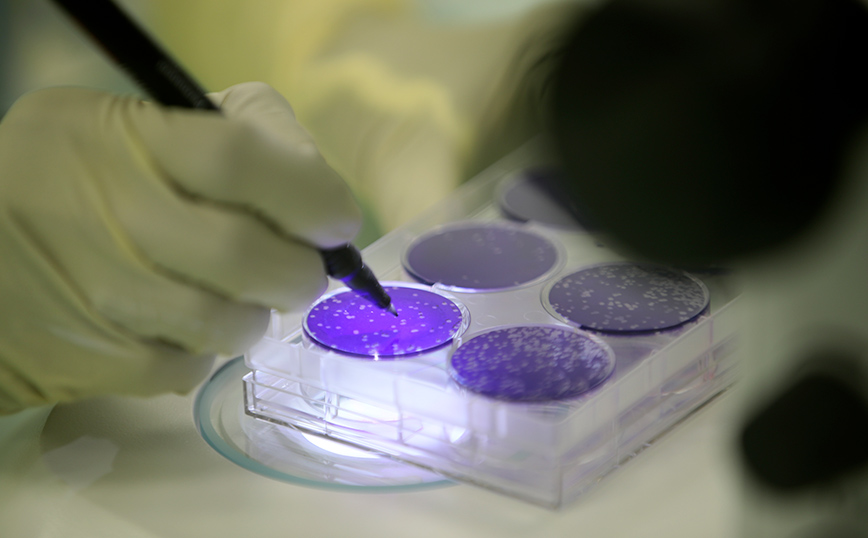

Το εμβόλιο κατά της COVID-19 της γαλλο-αυστριακής φαρμακευτικής εταιρείας Valneva εγκρίθηκε από την αρμόδια ρυθμιστική αρχή της Βρετανίας, όπως αναφέρει η ίδια σε ανακοίνωσή της. «Το εμβόλιο κατά της COVID-19 που αναπτύχθηκε από την Valneva έλαβε σήμερα την έγκρισης της Ρυθμιστικής Υπηρεσίας Φαρμάκων και Προϊόντων Υγείας (MHRA)», αναφέρει η υπηρεσία αυτή σε ανακοίνωσή της, στην οποία επισημαίνει ότι η βρετανική ρυθμιστική αρχή είναι η πρώτη στον κόσμο που το ενέκρινε.
Το εμβόλιο της Valneva έχει ήδη λάβει έγκριση για επείγουσα χρήση στο Μπαχρέιν, το οποίο έχει αγοράσει ένα εκατομμύριο δόσεις.
Επίσης η γαλλο-αυστριακή φαρμακευτική εταιρεία έχει ήδη υπογράψει συμφωνία με την Ευρωπαϊκή Επιτροπή για την προμήθεια μέγιστου αριθμού 60 εκατομμυρίων δόσεων σε δύο χρόνια, το 2022 και το 2023, όπως μεταδίδει το Γαλλικό Πρακτορείο και το Αθηναϊκό Πρακτορείο Ειδήσεων.
Το VLA2001 της Valneva είναι το έκτο εμβόλιο κατά της νόσου που προκαλεί ο νέος κορονοϊός που εγκρίθηκε στη Βρετανία, έπειτα από αυτά των AstraZeneca, Pfizer, Moderna, το μονοδοσικό της Janssen (Johnson & Johnson) και αυτό της Novavax.
«Η ανεξάρτητη επιτροπή φαρμάκων για χρήση από τον άνθρωπο και η ομάδα εργασίας της ειδικών για την COVID-19 εξέτασαν επιμελώς τις διαθέσιμες αποδείξεις και (…) η έκθεση οφέλους/κινδύνου είναι θετική», αναφέρει στην ανακοίνωση ο καθηγητής Μουνίρ Πιρμοχάμεντ, που είναι πρόεδρος της επιτροπής αυτής.
Το εμβόλιο της Valneva θα μπορεί να χρησιμοποιηθεί στη Βρετανία σε άτομα ηλικίας 18 ως 50 ετών. Η χορήγηση της δεύτερης δόσης του εμβολίου θα πρέπει να απέχει τουλάχιστον 28 ημέρες από αυτήν της πρώτης δόσης του.
Το εμβόλιο αυτό μπορεί να αποθηκευτεί σε θερμοκρασία συμβατικών ψυγείων, κάτι το οποίο διευκολύνει την χρήση του.
Η Βρετανία έχει πληγεί σκληρά από την πανδημία του νέου κορονοϊού, καθώς θρηνεί περισσότερα από 171.000 νεκρούς. Ποσοστό μεγαλύτερο από το 92% του πληθυσμού του Ηνωμένου Βασιλείου ηλικίας 12 ετών και άνω έχει λάβει μια πρώτη δόση εμβολίου κατά της COVID-19, 86,2% μια δεύτερη δόση και 67,8% μια αναμνηστική δόση.